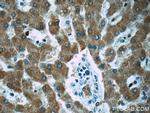
ZAK Antibody in Immunohistochemistry (Paraffin) (IHC (P))

Search
Proteintech
ZAK Polyclonal Antibody
{{$productOrderCtrl.translations['antibody.pdp.commerceCard.promotion.promotions']}}
{{$productOrderCtrl.translations['antibody.pdp.commerceCard.promotion.viewpromo']}}
{{$productOrderCtrl.translations['antibody.pdp.commerceCard.promotion.promocode']}}: {{promo.promoCode}} {{promo.promoTitle}} {{promo.promoDescription}}. {{$productOrderCtrl.translations['antibody.pdp.commerceCard.promotion.learnmore']}}
产品信息
14945-1-AP
宿主/亚型
分类
类型
抗原
偶联物
形式
浓度
规格
保存条件
运输条件
产品详细信息
Immunogen sequence: MSSLGASFV QIKFDDLQFF ENCGGGSFGS VYRAKWISQD KEVAVKKLLK IEKEAEILSV LSHRNIIQFY GVILEPPNYG IVTEYASLGS LYDYINSNRS EEMDMDHIMT WATDVAKGMH YLHMEAPVKV IHRDLKSRNV VIAADGVLKI CDFGASRFHN HTTHMSLVGT FPWMAPEVIQ SLPVSETCDT YSYGVVLWEM LTREVPFKGL EGLQVAWLVV EKNERLTIPS SCPRSFAELL HQCWEADAKK RPSFKQIISI LESMSNDTSL PDKCNSFLHN KAEWRCEIEA TLERLKKLER DLSFKEQELK ERE (1-312 aa encoded by BC001401)
靶标信息
ZAK is a leucine zipper-containing mitogen-activated protein related to the MLKs in both sequence and function. Like the MLKs and other MAP3Ks, ZAK activates MAP2Ks. ZAK is a member of the MAPKKK family of signal transduction molecules and encodes a protein with an N-terminal kinase catalytic domain, followed by a leucine zipper motif and a sterile-alpha motif. This magnesium-binding protein forms homodimers and is located in the cytoplasm. The protein mediates gamma radiation signaling leading to cell cycle arrest and activity of this protein plays a role in cell cycle checkpoint regulation in cells. The protein also has pro-apoptotic activity. Alternate transcriptional splice variants, encoding different isoforms, have been characterized.
仅用于科研。不用于诊断过程。未经明确授权不得转售。